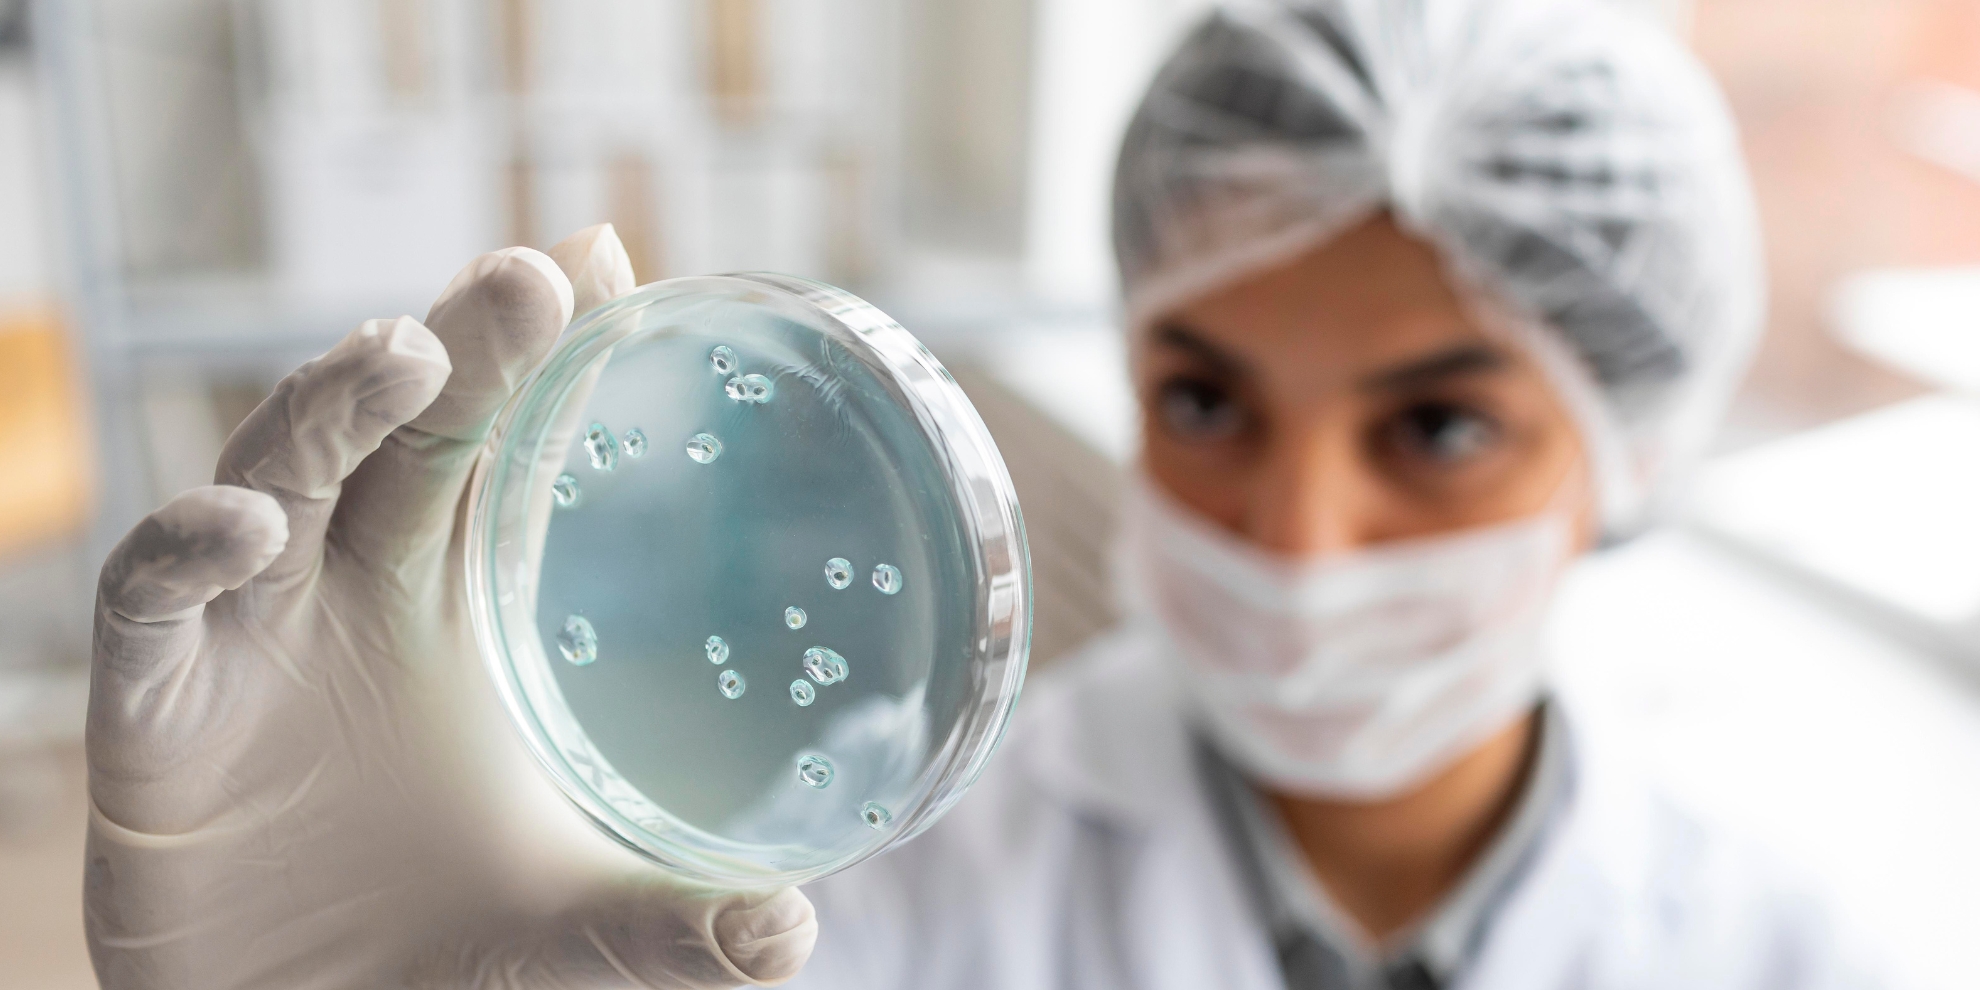
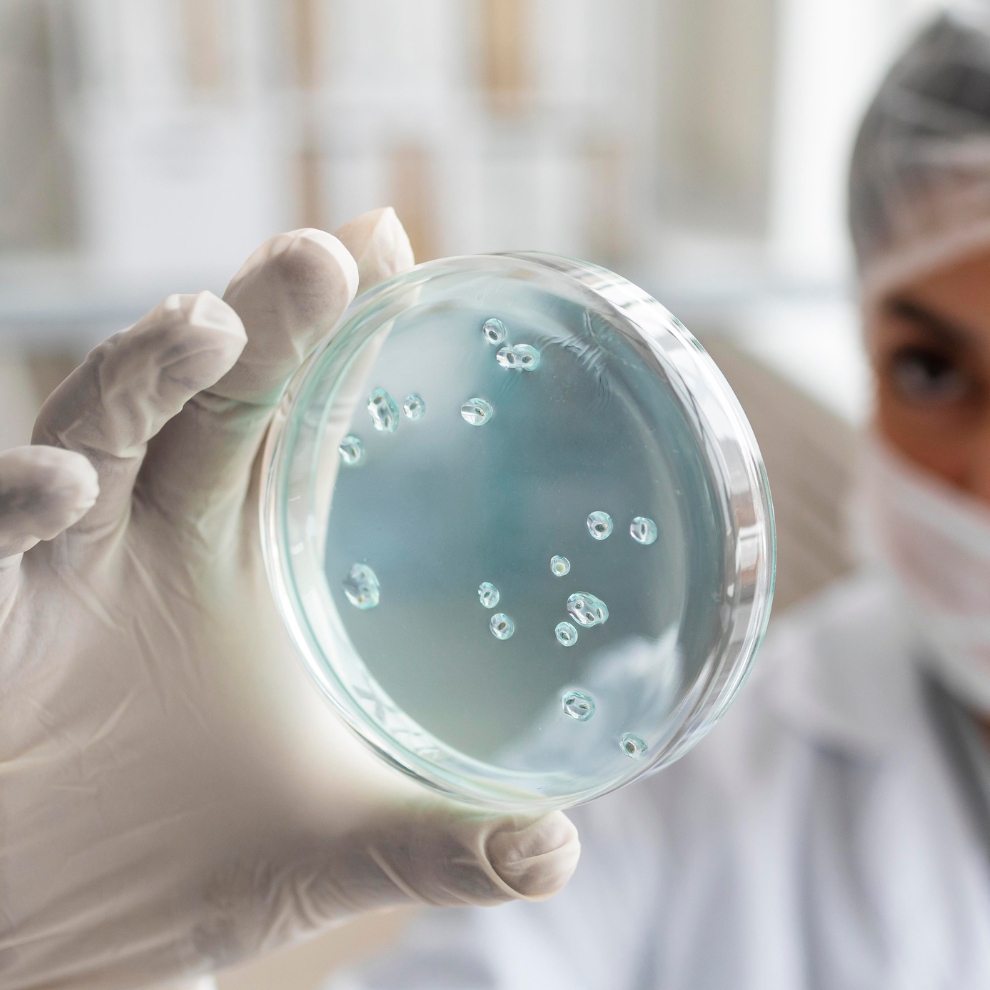

Curs "Actualitzacions en el diagnòstic i l’epidemiologia de les malalties infeccioses"

Obertes les inscripcions al curs “Actualitzacions en el diagnòstic i l’epidemiologia de les malalties infeccioses” desenvolupat pel Servei de Microbiologia i la Unitat de Malalties Infeccioses de Sant Pau conjuntament amb el Campus d’Aprenentatge amb l’objectiu de donar una visió actualitzada de tots aquells aspectes que poden redundar en una millor praxis diària i per donar visibilitat a temes d'investigació punters.
El curs, dirigit a facultatius/ves especialistes en Microbiologia i Parasitologia o Medicina Interna; Biòlegs en Ciències de la salut especialistes en Microbiologia i Parasitologia; Farmacèutics/es especialistes en Microbiologia i Parasitologia i Tècnics/ques Grau Superior en Laboratori de diagnòstic clínic interessats en la Patologia Infecciosa i la Microbiologia Clínica, tindrà lloc del 20 d'octubre de 2025 al 17 de juny de 2026, de 15 h a 16:30 h a la Facultat de Medicina de la UAB.
Pel que fa a l’acreditació, el curs, ha estat acreditat amb 3.5 crèdits de formació. Per a l’obtenció dels crèdits es requerirà una assistència mínima del 80% de les sessions.
Pots fer la inscripció prèvia enviant un correu electrònic a fnavarror@santpau.cat indicant el teu nom, lloc de treball, càrrec, direcció personal i professional, telèfon i correu electrònic.
Trobaràs el programa del curs amb tota la informació aquí.
#MésTalent











